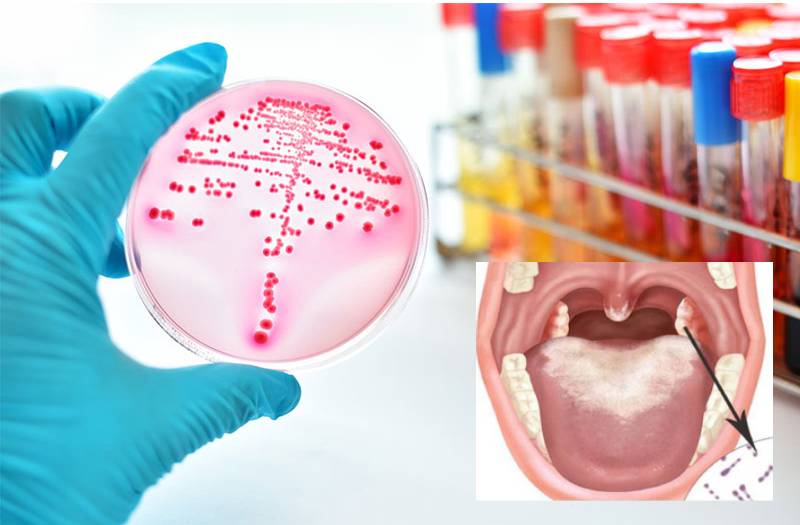
Xét nghiệm bạch hầu để làm gì? Khi nào nên xét nghiệm? 1

Dược sĩ Đại học có nhiều năm kinh nghiệm trong việc tư vấn Dược phẩm và hỗ trợ giải đáp thắc mắc về Bệnh học. Hiện đang là giảng viên cho Dược sĩ tại Nhà thuốc Long Châu.
Quỳnh Loan
06/07/2025
Mặc định
Lớn hơn
Bạch hầu là bệnh truyền nhiễm nguy hiểm có thể gây biến chứng tim, thần kinh và thậm chí tử vong nếu không được phát hiện sớm. Xét nghiệm bạch hầu là phương pháp quan trọng giúp chẩn đoán bệnh chính xác, kiểm soát nguồn lây và hỗ trợ điều trị hiệu quả. Bài viết sau sẽ giúp bạn hiểu rõ xét nghiệm bạch hầu để làm gì và thời điểm nào nên thực hiện xét nghiệm để phòng bệnh hiệu quả cho bản thân và cộng đồng.
Bệnh bạch hầu do vi khuẩn Corynebacterium diphtheriae gây ra, thường lây qua đường hô hấp và có tốc độ lây lan nhanh nếu không được kiểm soát. Trong bối cảnh xuất hiện nhiều ổ dịch rải rác, việc xét nghiệm bạch hầu là yếu tố then chốt để phát hiện sớm, xử lý kịp thời và ngăn ngừa lây nhiễm.
Bạch hầu là bệnh truyền nhiễm cấp tính nguy hiểm do vi khuẩn Corynebacterium diphtheriae gây ra. Vi khuẩn này có khả năng tiết độc tố tấn công tim, thận và hệ thần kinh, gây tử vong nếu không được điều trị kịp thời. Mặc dù vắc xin phòng bệnh bạch hầu đã giúp giảm mạnh số ca mắc nhưng nguy cơ lây lan vẫn còn, đặc biệt ở nhóm chưa tiêm phòng đầy đủ. Do đó, xét nghiệm bạch hầu đóng vai trò quan trọng trong phát hiện sớm, kiểm soát dịch và bảo vệ sức khỏe cộng đồng.
Ở giai đoạn đầu, bạch hầu thường gây đau họng, sốt nhẹ, ho - các triệu chứng dễ nhầm lẫn với viêm họng, cảm lạnh. Xét nghiệm bạch hầu giúp bác sĩ xác định chính xác sự hiện diện của vi khuẩn, từ đó phân biệt với các bệnh lý khác và đưa ra hướng điều trị phù hợp.
Các phương pháp như nuôi cấy vi khuẩn hay xét nghiệm PCR có độ đặc hiệu cao, giúp tránh bỏ sót ca bệnh. Điều này đặc biệt quan trọng với những người có yếu tố nguy cơ cao như từng tiếp xúc với người nghi nhiễm hoặc sống trong vùng có dịch.
Bạch hầu lây qua đường hô hấp hoặc tiếp xúc gần với người nhiễm bệnh. Trong nhiều trường hợp, người mang vi khuẩn không có triệu chứng rõ rệt nhưng vẫn có khả năng lây lan. Xét nghiệm giúp phát hiện sớm những trường hợp này để thực hiện cách ly và phòng ngừa lây nhiễm cộng đồng.
Không phải tất cả các chủng vi khuẩn bạch hầu đều sản sinh độc tố. Xét nghiệm bạch hầu giúp xác định độc lực của vi khuẩn để bác sĩ quyết định có cần dùng huyết thanh kháng độc tố hay không.
Xét nghiệm còn được dùng để kiểm tra hiệu quả điều trị, đánh giá vi khuẩn đã bị loại bỏ hoàn toàn hay chưa, từ đó điều chỉnh phác đồ nếu cần thiết.
Dù vắc xin bạch hầu đã làm giảm tỷ lệ mắc bệnh trên toàn cầu nhưng giám sát dịch tễ vẫn cần thiết. Xét nghiệm giúp phát hiện các ca nhiễm rải rác, đặc biệt ở những khu vực có tỷ lệ tiêm chủng thấp. Nhờ đó, các chiến dịch tiêm phòng có thể được triển khai đúng thời điểm, bảo vệ miễn dịch cộng đồng.

Xét nghiệm bạch hầu cần được thực hiện kịp thời để chẩn đoán chính xác và ngăn ngừa nguy cơ lây lan trong cộng đồng. Người dân nên chủ động xét nghiệm khi có các dấu hiệu nghi ngờ như đau họng kéo dài, sốt nhẹ, khàn tiếng hoặc xuất hiện giả mạc màu trắng xám ở amidan và hầu họng. Giả mạc này có thể gây chảy máu khi bóc tách và kèm theo biểu hiện khó nuốt hoặc khó thở. Trong những trường hợp nặng, cổ họng có thể sưng to tạo thành hiện tượng "cổ bò" - một dấu hiệu đặc trưng của bạch hầu.
Ngoài các dấu hiệu lâm sàng, xét nghiệm bạch hầu cũng nên được thực hiện ở những người có nguy cơ cao như:

Trong các chiến dịch sàng lọc cộng đồng khi dịch bùng phát, xét nghiệm đóng vai trò xác minh ca nghi ngờ và truy vết nguồn lây. Ngay cả khi không có biểu hiện rõ rệt, việc lấy mẫu dịch tiết hầu họng hoặc nuôi cấy vi khuẩn vẫn giúp phát hiện sớm ca bệnh và hạn chế nguy cơ lan rộng.
Xét nghiệm cũng được chỉ định trong các trường hợp có biểu hiện tổn thương tim hoặc hệ thần kinh không rõ nguyên nhân. Độc tố bạch hầu có thể gây viêm cơ tim hoặc tổn thương dây thần kinh dẫn đến liệt tạm thời nếu không được phát hiện sớm.
Thời điểm tối ưu để xét nghiệm là trong vòng 48 - 72 giờ sau khi xuất hiện triệu chứng đầu tiên. Việc xét nghiệm đúng lúc không chỉ giúp tăng độ chính xác mà còn góp phần điều trị hiệu quả và kiểm soát dịch bệnh kịp thời.
Phòng bệnh bạch hầu là biện pháp cần thiết và hiệu quả nhất để bảo vệ sức khỏe cộng đồng.
Cách phòng bệnh quan trọng hàng đầu là tiêm vắc xin giải độc tố bạch hầu. Đây là phương pháp đơn giản nhưng có hiệu quả lâu dài trong việc ngăn ngừa nguy cơ mắc bệnh. Trẻ nhỏ từ 2 tháng tuổi cần được tiêm vắc xin đúng lịch để đảm bảo tạo miễn dịch sớm. Người lớn chưa từng tiêm chủng hoặc không được tiêm nhắc lại sau nhiều năm cũng nên chủ động tiêm phòng.

Trong trường hợp có dịch bùng phát tại cộng đồng, việc xác định sớm ổ dịch, cách ly người bệnh và theo dõi người tiếp xúc gần là điều bắt buộc nhằm tránh lây lan diện rộng. Những người có nguy cơ cao như trẻ em người chưa tiêm chủng đầy đủ hoặc người sống tại vùng dịch cần được chăm sóc đặc biệt và theo dõi sát sao.
Khi có triệu chứng nghi ngờ như sốt, đau họng, giả mạc ở họng hoặc khàn tiếng, người dân nên đi xét nghiệm sớm để bác sĩ có thể chẩn đoán chính xác và điều trị kịp thời. Nếu để bệnh diễn tiến nặng có thể gây tổn thương tim, thận hoặc hệ thần kinh đe dọa đến tính mạng.
Chủ động tiêm phòng là cách bảo vệ bản thân và cộng đồng trước bệnh bạch hầu. Trung tâm Tiêm chủng Long Châu hiện cung cấp đầy đủ các loại vắc xin phòng bệnh cho trẻ nhỏ và người lớn, trong đó bao gồm vắc xin phòng bệnh bạch hầu - ho gà - uốn ván với quy trình tiêm an toàn và đội ngũ chuyên môn giàu kinh nghiệm. Người dân đến tiêm đúng lịch để tạo miễn dịch bền vững ngăn ngừa nguy cơ bùng phát dịch và góp phần xây dựng cộng đồng khỏe mạnh.
Dược sĩ Đại họcNguyễn Mỹ Huyền
Dược sĩ Đại học có nhiều năm kinh nghiệm trong việc tư vấn Dược phẩm và hỗ trợ giải đáp thắc mắc về Bệnh học. Hiện đang là giảng viên cho Dược sĩ tại Nhà thuốc Long Châu.